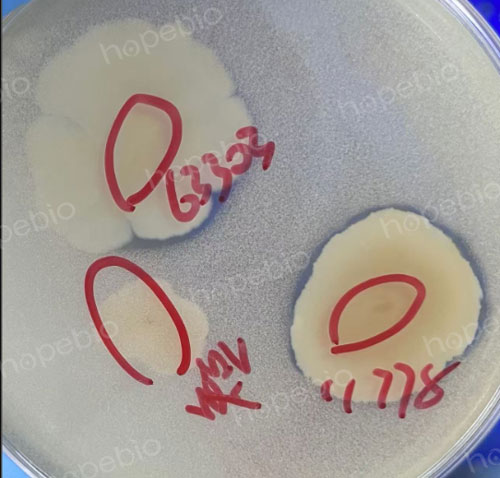

海博微信公众号
海博微信公众号
 海博天猫旗舰店
海博天猫旗舰店


 海博微信公众号
海博微信公众号
 海博天猫旗舰店
海博天猫旗舰店




一、原理
蜡样芽孢杆菌是一种常见的细菌,具有较强的分解有机物的能力。在含有酪氨酸的培养基(酪氨酸分解平板)上,蜡样芽孢杆菌能够分泌特定的酶,这些酶可以分解酪氨酸。酪氨酸是一种氨基酸,正常情况下不易被降解,但在蜡样芽孢杆菌的作用下,它被分解成小分子物质。这种分解反应会导致菌落周围的培养基颜色变浅,形成明显的透明圈。透明圈的出现说明细菌具有分解酪氨酸的能力。
二、用途
观察蜡样芽孢杆菌在酪氨酸分解平板上的透明圈现象,具有多种应用价值:
细菌鉴定:通过是否形成透明圈,可以初步鉴别蜡样芽孢杆菌及其相关菌种,作为微生物分类和鉴定的一种辅助方法。
酶活性研究:透明圈的大小可以反映细菌分泌酶的活性强弱,适用于研究微生物代谢产物,或筛选高效分解酶的菌株。
食品与环境检测:由于蜡样芽孢杆菌与食源性疾病相关,检测其分解酪氨酸的能力有助于评估食品或环境样品中的潜在污染。
三、用法
在实验中,观察蜡样芽孢杆菌分解酪氨酸的步骤大致如下:
1. 制备培养基:配制含有酪氨酸的分解平板,通常还需要调整适合细菌生长的pH值和营养成分。
2. 接种细菌:用无菌操作将蜡样芽孢杆菌接种到平板表面。
3. 培养:将平板置于适宜的温度(通常是30–37°C)下培养7天。
4. 观察现象:培养结束后,观察菌落周围是否形成清晰的透明圈。透明圈越明显,说明细菌分解酪氨酸的能力越强。
四、 结论
蜡样芽孢杆菌在酪氨酸分解平板上形成透明圈的现象,直观地反映了其分解酪氨酸的代谢能力。通过这一简单的实验,可以快速评估细菌的特性和酶活性。这种方法不仅在微生物学基础研究中有广泛应用,还在食品安全、环境检测以及工业菌种筛选等领域发挥着重要作用。随着研究的深入,类似的分解实验将在更多领域展现更大的应用潜力。
下图为蜡样芽孢杆菌在酪氨酸分解平板上的生长
注:本文属海博生物原创,未经允许不得转载。
下一篇:没有了!
| 相关文章: | |



